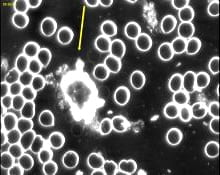
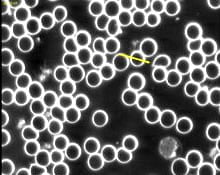

Live Blood Cell Analysis

LIVE BLOOD CELL ANALYSIS: TESTING
The test below involved a male, in his mid thirties that was in constant exposure to high levels of EMF. Like many men these days he was in close proximity to electrical equipment all day and spent a lot of time with computers and game consoles. On top of this he had a very poor diet and did not exercise.
The subject was given a Blushield Portable to carry around with him at all times. A Blushield Plug-in model was also installed at his home and was kept going 24/7. No other changes were made to diet or lifestyle during the testing period which was from 11th January 2012 till the 14th of March 2012.